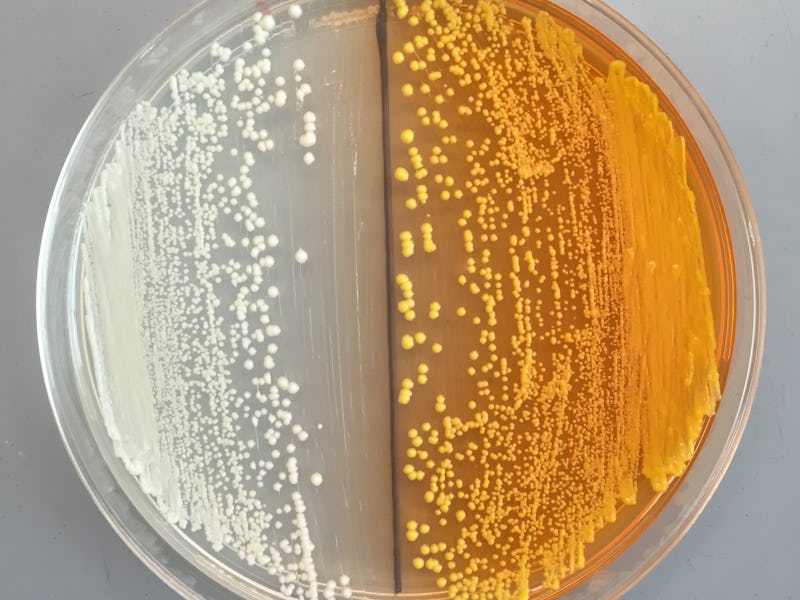

Bioengineers Alter Yeast to Allow for Home-Brewed Drugs
Morphine - just like Mom used to make.
Yeast, as any brew fan worth his beer nuts knows, are the key micro-machines for turning sugar into alcohol. But thanks to a discovery by University of Berkeley and Concordia University bioengineers, yeast's hunger for sugar can be used to create not just alcohol, but morphine and heroin.
The aim of this work isn’t to simply turn yeast colonies into tiny poppy fields. Rather, the scientists who are rerouting yeast’s chemical pathways hope to spur cheaper pharmaceutical manufacturing have a slightly loftier goal, discovering new therapeutic drugs. The latest bioengineered Lego brick snapped in place, the researchers reported in the journal Nature Chemical Biology on Monday, the yeast synthesizing reticuline (a poppy compound) from tyrosine (derivative of the sugar glucose).
It's a discovery fraught with both potential and peril. "We're likely looking at a timeline of a couple of years, not a decade or more, when sugar-fed yeast could reliably produce a controlled substance," UC Berkeley's John Dueber said in a press release.
Not everyone agrees that heroin mass-produced in such a way is right around the corner - some experts told The New York Times that warnings about “Brewing Bad” yeast labs are alarmist. Others were worried that too-forceful restrictions might birth a black market for DNA synthesis. (The creativity of some drug enthusiasts should not be discounted — look no further than the marijuana making its way to weed-dry states in marshmallows, lollipops, and other confections.)
By voicing their concerns, scientists like Dueber and federal agents like Edward You (minter of the phrase “Brewing Bad”) hope to make sure no one is be surprised if these synthetic drugs start popping up. “The field is moving surprisingly fast, and we need to be out in front so that we can mitigate the potential for abuse,” he said. The D.E.A. might not care so much about kegfuls of heroin homebrew yet (they told The Times as much) but if lots of Saccharomyces cerevisiae start churning out opiates, at least Dueber gets to say he told them so.